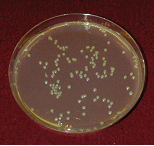
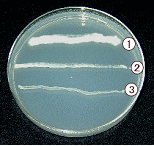
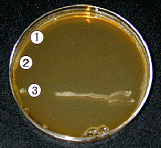
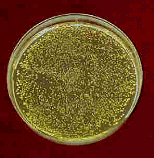

shell misutシェルミスト |
|
 |
いつも、家族や周囲に気配りしてくださるおじいさん。 この、除菌・消臭剤は100%天然素材の優れものです。
消臭剤もお孫さんやペットにも安全で、、何より環境に優しい物を選んで下さい。ホタテの貝がらから、すごいパワーを発見・発明した科学者に私は、敬意を払います。 ホタテを見ても、お酒のつまみにしか見えない私。(^_^;) エッ?おじいさんも?ですよね〜。 ちなみに、ミストはホタテの臭いなんてしませんからご安心を。
|
|
|

150ミリリットル 原産国 日本
|
Shell Power!「シェルミスト」
嫌な臭いを香りなんかでごまかさない!
100%天然素材のほたて貝殻焼成セラミックス水溶液使用
だから人に優しい、もちろんペットにも。
新発想の除菌・消臭ミスト |
|
スタイル シェル ミストは、私たちが食しているほたて貝の貝殻を、0.2mm以下に粉砕、1050℃の高温で特殊焼成し、天然水と混ぜ合わせてできた除菌・消臭剤です。
ほたて貝殻には研究結果で■除菌効果■消臭効果■抗菌効果■防虫効果などを持ち合わせていることがわかっています。今後、ほたて貝殻焼成セラミックスはさまざまな分野で応用され、活躍が期待されています。
100%天然素材ですので、人にも環境にも安心してお使いいただけます。 |
|
<シェルミストの効果を実感できる使用例>
あし・手
足の嫌な臭い(水虫)、靴やブーツの中の臭い消し、手の除菌、わきの嫌な臭い
キッチン
キッチンのまわりやキッチン用品(まな板・スポンジ・ふきん・包丁など)
生ゴミ
生ゴミや三角コーナーに直接ミスト
たばこ
たばこ臭や灰皿、たばこ臭がついた服など
ペット
ペットの尿やフンのにおい消し
ルーム
カーテン、絨毯、部屋干し時の気になる臭いに
トイレ
トイレや便器に直接ミスト
くるま
くるまにこもったたばこ臭や食べ物などの臭い消しに |
|
ホタテ貝殻セラミックスの抗菌試験結果
ホタテ貝殻セラミックス水溶液添加の場合の各種菌の生菌率(%)
供 試 菌 |
0 分 |
1分 |
5分 |
10分 |
15分 |
30分 |
7日 |
大 腸 菌 |
36 |
0.4 |
<10-3 |
<10-4 |
- |
- |
- |
黄色ブドウ球菌 |
62 |
0.6 |
<10-4 |
<10-4 |
- |
- |
- |
サルモネラ菌 |
22 |
<10-2 |
<10-4 |
<10-4 |
- |
- |
- |
水 虫 菌 |
100 |
- |
- |
- |
- |
- |
0 |
MRSA |
100 |
- |
4.3 |
- |
0.02 |
0.0004 |
- |
*実験に用いたホタテ貝殻セラミックス水溶液は製品の「チャフクリーン」と同等の濃度です。
ホタテ貝殻を高温で特殊熱処理した粉末を「ホタテ貝殻セラミックス」と言います。この粉末を水に溶かすと、0.15%程度溶解し、pHは12.5程度になります。 |
|
大腸菌の抗菌試験
大腸菌の場合は、ホタテ貝殻セラミックス水溶液を入れた瞬間に、生菌率は34%、1分後に0.4%の即効性のある抗菌効果を示します。黄色ブドウ球菌、サルモネラ菌も同様です。
|
|
 |
写真1 生理食塩水 |
|
写真2 ホタテ貝殻セラミックス水溶液添加 |
|
|
水虫菌の抗菌試験
水虫菌については、日本人の多くが持つ,Arthroderma vanbreuseghemii , Arthroderma benhamiae(白癬菌)の2種類について実験したところ、ホタテ貝殻セラミックス水溶液を加えた場合は、生えません。写真1は、ホタテ貝殻セラミックス水溶液無添加の場合で上から、Arthroderma
vanbreuseghemii (1)(白癬菌),Arthroderma benhamiae(2)(白癬菌)、Saccharomyces cerevisiae
(3)(酵母菌)で、写真2はホタテ貝殻セラミックス水溶液添加の場合で、酵母菌には影響が無く、ひょっとしたら、善玉菌には効かないのかも(?)との期待ができます。
|
1.白癬菌
2.水虫菌
3.酵母菌
|
|
写真1
ホタテ貝殻セラミックス水溶液無添加 |
|
写真2
ホタテ貝殻セラミックス水溶液添加(1分後) |
|
|
ホタテ貝殻セラミックスの抗菌機能(MRSA)
メチシリン耐性黄色ブドウ球菌(MRSA)に対して医学界は白旗を揚げた(読売新聞、2001.7.4)。これ以上抗生物質に対して強い菌を作らないことで、今のところ対応策はありません。このようなメチシリン耐性黄色ブドウ球菌(MRSA)に対してホタテ貝殻セラミックスは抗菌効果を持ちます。院内感染対策において、不可能な現実が、可能になるかも知れません。病院における院内感染防止対策製品の洗浄剤等や医薬品として応用できそうです。
|
白癬菌
水虫菌
酵母菌
が→
|
 |
ホタテ貝殻セラミックス水溶液無添加 |
|
ホタテ貝殻セラミックス水溶液添加 |
|
|
1980円(税込み) |
|
|
|
 |